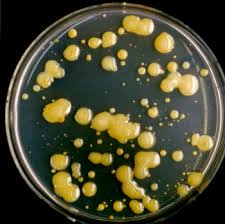
Image result for Xanthomonas campestris,

in 2016, CZECH REPUBLIC; new citation of work of Sergei A. Ostroumov et al. Toxicity of gold nanoparticles for plants in experimental aquatic system. Moscow University Biological Sciences Bulletin
**
The cited article of S.A.Ostroumov et al.:
Ostroumov, S.A., Poklonov, V.A., Kotelevtsev, S.V., Orlov, S.N. 2014. Toxicity of gold nanoparticles for plants in experimental aquatic system. Moscow University Biological Sciences Bulletin, 69(3): 108–112. Available at:
https://www.researchgate.net/publication/265551300 ;
http://link.springer.com/10.3103/S0096392514030080. [2016-09-15].
**
Cited in:
MENDELNET 2016 736 | Page
ANTIBACTERIAL EFFECT OF SELECTED NANOPARTICLES AS REVEALED BY DOUBLING TIME OF TREATED XANTHOMONAS CAMESTRIS PV. CAMPESTRIS CULTURES.
JAKUB PECENKA1, KATERINA SVOBODOVA2, ALES EICHMEIER1, MIROSLAV BARANEK1 1 Mendeleum – Institute of Genetics Mendel University in Brno Valticka 337, 691 44 Lednice 2 Laboratory of Environmental Biotechnology Institute of Microbiology of the CAS,v.v.i. Videnska 1083, 14220 Prague, CZECH REPUBLIC; jakubpecenka@gmail.com;
http://5bio5.blogspot.ru/2017/01/2016-czech-republic-new-citation-of.html
Abstract:
Besides many possibilities of applications of nanoparticles in the field of medicine, diagnostics, molecular biology, bioorganic chemistry or remediation of environment, there is also a potential of employment of nanoparticles as a tool for elimination and control of bacteria invading plant tissue. In this experiment an antibacterial activity of selected nanoparticles based on silver, gold and bimetallic silver/copper was tested on bacteria Xanthomonas campestris pv. campestris (Xcc) (strain 1279a). The strongest inhibitory effect represented by doubling time of treated cultures was measured in the presence of the smallest silver nanoparticles (9 nm) at the highest concentration (5 ppm).
Key Words: Nanoparticles, Xanthomonas campestris, doubling time, antibacterial effect

**
REFERENCES
Ahmed, K.B.A., Raman, T., Veerappan, A. 2016. Future prospects of antibacterial metal nanoparticles as enzyme inhibitor. Materials Science and Engineering [Online], 68: 939–947. Available at: http://linkinghub.elsevier.com/retrieve/pii/S0928493116306026. [2016-09-15]. Barrena, R., Casals, E., Colón, J., Font, X., Sánchez, A., Puntes, V. 2009. Evaluation of the ecotoxicity of model nanoparticles. Chemosphere [Online], 75(7): 850–857. Available at: http://linkinghub.elsevier.com/retrieve/pii/S0045653509001416. [2016-09-15]. Borm, P., Klaessig, F., Landry, T., Moudgil, B., Pauluhn, J., Thomas, K. 2006. Wood, S. Research Strategies for Safety Evaluation of Nanomaterials, Part V: Role of Dissolution in Biological Fate and Effects of Nanoscale Particles. Toxicological Sciences [Online], 90(1): 23-32. Available at: http://www.toxsci.oxfordjournals.org/cgi/doi/10.1093/toxsci/kfj084. [2016-09-15]. Franci, G., Falanga, A., Galdiero, S., Palomba, L., Rai, M., Morelli, G., Galdiero, M. 2015. Silver Nanoparticles as Potential Antibacterial Agents. Molecules [Online], 20(5): 8856-8874. Available at: http://www.mdpi.com/1420-3049/20/5/8856/. [2016-09-15]. Giannousi, K., Lafazanis, K., Arvanitidis, J., Pantazaki, A., Dendrinou-Samara, C. 2014. Hydrothermal synthesis of copper based nanoparticles: Antimicrobial screening and interaction with DNA. Journal of Inorganic Biochemistry [Online], 133: 24–32. Available at: http://linkinghub.elsevier.com/retriev e/pii/S0162013413003395. [2016-09-15]. Hrdinová, Z. 2014. The importance of nanotechnology in food. Brno, Bachelor Thesis. Mendel University in Brno. Supervisor: Soňa Křížková. Jo, Y., Kim, B.H., Jung, B. 2009. Antifungal Activity of Silver Ions and Nanoparticles on Phytopathogenic Fungi. Plant Disease [Online], 93(10): 1037-1043. Available at: http://apsjournals.apsnet.org/doi/abs/10.1094/PDIS-93-10-1037. [2016-09-15]. Mu, H., Liu Q., Niu, H., Sun, Y., Duan, J. 2016. Gold nanoparticles make chitosan–streptomycin conjugates effective towards Gram-negative bacterial biofilm. RSC Advances [Online], 6(11): 8714- 8721. Available at: http://xlink.rsc.org/?DOI=C5RA22803D. [2016-09-15]. Ngomsik, A., Bee, A., Draye, M., Cote, G., Cabuil, V. 2005. Magnetic nano- and microparticles for metal removal and environmental applications: a review. Comptes Rendus Chimie [Online], 8(6-7): 963–970. Available at: http://linkinghub.elsevier.com/retrieve/pii/S1631074805000081. [2016-09-15]. Ostroumov, S.A., Poklonov, V.A., Kotelevtsev, S.V., Orlov, S.N. 2014. Toxicity of gold nanoparticles for plants in experimental aquatic system. Moscow University Biological Sciences Bulletin [Online], 69(3): 108–112. Available at: http://link.springer.com/10.3103/S0096392514030080. [2016-09-15]. Paret, M.L., Vallad, G.E., Averett, D.R., Jones, J.B., Olson, S.M. 2013. Photocatalysis: Effect of LightActivated Na,noscale Formulations of TiO 2 on Xanthomonas perforans and Control of Bacterial Spot of Tomato. Phytopathology [Online], 103(3): 228-236. Available at: http://apsjournals.apsnet.org/doi/abs/10.1094/PHYTO-08-12-0183-R. [2016-09-15]. Park, Y.J., Lee, B.M., HO-Hahn, J., Lee, G.B., Park, D.S. 2004. Sensitive and specific detection of Xanthomonas campestris pv. campestris by PCR using species-specific primers based on hrpF gene MENDELNET 2016 741 | Page sequences. Microbiological Research [Online], 159(4): 419–423. Available at: http://linkinghub.elsevier.com/retrieve/pii/S0944501304000734. [2016-09-15]. Qian, W., Jia, Y., Ren, S., He., Y., Feng, J., Lu, L., Sun, Q., Ying, G., Tang, D., Wu, H.T.W., Hao, P., Wang, L. ,Jiang, B., Zeng, S., Gu, W., Lu, G., Rong, Li., Tian, Y., Yao, Z., Fu, G., Chen, B., Fang, R., Qiang, B., Chen, Z., Zhao, G., Tang, J., He, C. 2005. Comparative and functional genomic analyses of the pathogenicity of phytopathogen Xanthomonas campestris pv. campestris. Genome Research [Online], 6(9): 757-767. Available at: http://www.genome.org/cgi/doi/10.1101/gr.3378705. [2016-09- 15]. Shrivastava, S., Bera, T., Roy, A., Singh, G., Ramachandrarao, P., Dash, D. 2007. Characterization of enhanced antibacterial effects of novel silver nanoparticles. Nanotechnology [Online], 18(22): 225103- x. Available at: http://stacks.iop.org/0957-4484/18/i=22/a=225103?key=crossref.c7262c016 de5476a6a6cca9b14e7b1dd. [2016-09-15]. Uheida, A., Iglesias, M., Fontàs, C., Hidalgo, M., Salvadó, V., Zhang, Y., Muhammed, M. 2006. Sorption of palladium(II), rhodium(III), and platinum(IV) on Fe3O4 nanoparticles. Journal of Colloid and Interface Science [Online], 301(2): 402-408. Available at: http://linkinghub.elsevier.com/retr ieve/pii/S0021979706004176. [2016-09-15]. Williams, P.,H. 1980. Black Rot: A Continuing. Plant Disease [Online], 64(8): 736-742. Available at: http://www.apsnet.org/publications/plantdisease/backissues/Documents/1980Articles/PlantDisease64n 08_736.pdf. [2016-09-15]
**
**
Scholar Alert: New citations to articles in Sergei Ostroumov's profile
[PDF] ANTIBACTERIAL EFFECT OF SELECTED NANOPARTICLES AS REVEALED BY DOUBLING TIME OF TREATED XANTHOMONAS CAMESTRIS PV. CAMPESTRIS …
J PECENKA, K SVOBODOVA, A EICHMEIER…
Abstract: Besides many possibilities of applications of nanoparticles in the field of medicine,
diagnostics, molecular biology, bioorganic chemistry or remediation of environment, there is
also a potential of employment of nanoparticles as a tool for elimination and control of
**diagnostics, molecular biology, bioorganic chemistry or remediation of environment, there is
also a potential of employment of nanoparticles as a tool for elimination and control of
The cited article of S.A.Ostroumov et al.:
Ostroumov, S.A., Poklonov, V.A., Kotelevtsev, S.V., Orlov, S.N. 2014. Toxicity of gold nanoparticles for plants in experimental aquatic system. Moscow University Biological Sciences Bulletin, 69(3): 108–112. Available at:
https://www.researchgate.net/publication/265551300 ;
http://link.springer.com/10.3103/S0096392514030080. [2016-09-15].
**
Cited in:
MENDELNET 2016 736 | Page
ANTIBACTERIAL EFFECT OF SELECTED NANOPARTICLES AS REVEALED BY DOUBLING TIME OF TREATED XANTHOMONAS CAMESTRIS PV. CAMPESTRIS CULTURES.
JAKUB PECENKA1, KATERINA SVOBODOVA2, ALES EICHMEIER1, MIROSLAV BARANEK1 1 Mendeleum – Institute of Genetics Mendel University in Brno Valticka 337, 691 44 Lednice 2 Laboratory of Environmental Biotechnology Institute of Microbiology of the CAS,v.v.i. Videnska 1083, 14220 Prague, CZECH REPUBLIC; jakubpecenka@gmail.com;
http://5bio5.blogspot.ru/2017/01/2016-czech-republic-new-citation-of.html
Abstract:
Besides many possibilities of applications of nanoparticles in the field of medicine, diagnostics, molecular biology, bioorganic chemistry or remediation of environment, there is also a potential of employment of nanoparticles as a tool for elimination and control of bacteria invading plant tissue. In this experiment an antibacterial activity of selected nanoparticles based on silver, gold and bimetallic silver/copper was tested on bacteria Xanthomonas campestris pv. campestris (Xcc) (strain 1279a). The strongest inhibitory effect represented by doubling time of treated cultures was measured in the presence of the smallest silver nanoparticles (9 nm) at the highest concentration (5 ppm).
Key Words: Nanoparticles, Xanthomonas campestris, doubling time, antibacterial effect
**
REFERENCES
Ahmed, K.B.A., Raman, T., Veerappan, A. 2016. Future prospects of antibacterial metal nanoparticles as enzyme inhibitor. Materials Science and Engineering [Online], 68: 939–947. Available at: http://linkinghub.elsevier.com/retrieve/pii/S0928493116306026. [2016-09-15]. Barrena, R., Casals, E., Colón, J., Font, X., Sánchez, A., Puntes, V. 2009. Evaluation of the ecotoxicity of model nanoparticles. Chemosphere [Online], 75(7): 850–857. Available at: http://linkinghub.elsevier.com/retrieve/pii/S0045653509001416. [2016-09-15]. Borm, P., Klaessig, F., Landry, T., Moudgil, B., Pauluhn, J., Thomas, K. 2006. Wood, S. Research Strategies for Safety Evaluation of Nanomaterials, Part V: Role of Dissolution in Biological Fate and Effects of Nanoscale Particles. Toxicological Sciences [Online], 90(1): 23-32. Available at: http://www.toxsci.oxfordjournals.org/cgi/doi/10.1093/toxsci/kfj084. [2016-09-15]. Franci, G., Falanga, A., Galdiero, S., Palomba, L., Rai, M., Morelli, G., Galdiero, M. 2015. Silver Nanoparticles as Potential Antibacterial Agents. Molecules [Online], 20(5): 8856-8874. Available at: http://www.mdpi.com/1420-3049/20/5/8856/. [2016-09-15]. Giannousi, K., Lafazanis, K., Arvanitidis, J., Pantazaki, A., Dendrinou-Samara, C. 2014. Hydrothermal synthesis of copper based nanoparticles: Antimicrobial screening and interaction with DNA. Journal of Inorganic Biochemistry [Online], 133: 24–32. Available at: http://linkinghub.elsevier.com/retriev e/pii/S0162013413003395. [2016-09-15]. Hrdinová, Z. 2014. The importance of nanotechnology in food. Brno, Bachelor Thesis. Mendel University in Brno. Supervisor: Soňa Křížková. Jo, Y., Kim, B.H., Jung, B. 2009. Antifungal Activity of Silver Ions and Nanoparticles on Phytopathogenic Fungi. Plant Disease [Online], 93(10): 1037-1043. Available at: http://apsjournals.apsnet.org/doi/abs/10.1094/PDIS-93-10-1037. [2016-09-15]. Mu, H., Liu Q., Niu, H., Sun, Y., Duan, J. 2016. Gold nanoparticles make chitosan–streptomycin conjugates effective towards Gram-negative bacterial biofilm. RSC Advances [Online], 6(11): 8714- 8721. Available at: http://xlink.rsc.org/?DOI=C5RA22803D. [2016-09-15]. Ngomsik, A., Bee, A., Draye, M., Cote, G., Cabuil, V. 2005. Magnetic nano- and microparticles for metal removal and environmental applications: a review. Comptes Rendus Chimie [Online], 8(6-7): 963–970. Available at: http://linkinghub.elsevier.com/retrieve/pii/S1631074805000081. [2016-09-15]. Ostroumov, S.A., Poklonov, V.A., Kotelevtsev, S.V., Orlov, S.N. 2014. Toxicity of gold nanoparticles for plants in experimental aquatic system. Moscow University Biological Sciences Bulletin [Online], 69(3): 108–112. Available at: http://link.springer.com/10.3103/S0096392514030080. [2016-09-15]. Paret, M.L., Vallad, G.E., Averett, D.R., Jones, J.B., Olson, S.M. 2013. Photocatalysis: Effect of LightActivated Na,noscale Formulations of TiO 2 on Xanthomonas perforans and Control of Bacterial Spot of Tomato. Phytopathology [Online], 103(3): 228-236. Available at: http://apsjournals.apsnet.org/doi/abs/10.1094/PHYTO-08-12-0183-R. [2016-09-15]. Park, Y.J., Lee, B.M., HO-Hahn, J., Lee, G.B., Park, D.S. 2004. Sensitive and specific detection of Xanthomonas campestris pv. campestris by PCR using species-specific primers based on hrpF gene MENDELNET 2016 741 | Page sequences. Microbiological Research [Online], 159(4): 419–423. Available at: http://linkinghub.elsevier.com/retrieve/pii/S0944501304000734. [2016-09-15]. Qian, W., Jia, Y., Ren, S., He., Y., Feng, J., Lu, L., Sun, Q., Ying, G., Tang, D., Wu, H.T.W., Hao, P., Wang, L. ,Jiang, B., Zeng, S., Gu, W., Lu, G., Rong, Li., Tian, Y., Yao, Z., Fu, G., Chen, B., Fang, R., Qiang, B., Chen, Z., Zhao, G., Tang, J., He, C. 2005. Comparative and functional genomic analyses of the pathogenicity of phytopathogen Xanthomonas campestris pv. campestris. Genome Research [Online], 6(9): 757-767. Available at: http://www.genome.org/cgi/doi/10.1101/gr.3378705. [2016-09- 15]. Shrivastava, S., Bera, T., Roy, A., Singh, G., Ramachandrarao, P., Dash, D. 2007. Characterization of enhanced antibacterial effects of novel silver nanoparticles. Nanotechnology [Online], 18(22): 225103- x. Available at: http://stacks.iop.org/0957-4484/18/i=22/a=225103?key=crossref.c7262c016 de5476a6a6cca9b14e7b1dd. [2016-09-15]. Uheida, A., Iglesias, M., Fontàs, C., Hidalgo, M., Salvadó, V., Zhang, Y., Muhammed, M. 2006. Sorption of palladium(II), rhodium(III), and platinum(IV) on Fe3O4 nanoparticles. Journal of Colloid and Interface Science [Online], 301(2): 402-408. Available at: http://linkinghub.elsevier.com/retr ieve/pii/S0021979706004176. [2016-09-15]. Williams, P.,H. 1980. Black Rot: A Continuing. Plant Disease [Online], 64(8): 736-742. Available at: http://www.apsnet.org/publications/plantdisease/backissues/Documents/1980Articles/PlantDisease64n 08_736.pdf. [2016-09-15]
**





